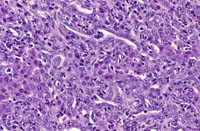
oval cell hyperplasia

The Digitized Atlas of Mouse Liver Lesions

Much of the work carried out by DTT is in support of the National Toxicology Program (NTP), an interagency partnership of the Food and Drug Administration, National Institute for Occupational Safety and Health, and NIEHS.
Visit the NTP WebsiteOval cell hyperplasia is typically seen in livers with multiple toxic changes as a result of treatment or infection as well as in mice treated with some hepatocarcinogens. Oval cells are small spindloid, oval, or round cells with scant cytoplasm. They usually appear initially in periportal and subcapsular areas. It has been suggested that they are derived from terminal biliary ductular cells (Hering canal cells), and they are believed capable of differentiating into hepatocytes or biliary cells.
At low magnification, oval cell hyperplasia appears as an increased cellularity in portal areas. Slightly higher magnification reveals that centrilobular hepatocyte hypertrophy is also present.
Oval cell hyperplasia, hepatocyte hypertrophy and karyomegaly,hepatocyte degeneration, and a pseudoinclusion (protusion of cytoplasm into the nucleus) in a hepatocyte nucleus (arrow).
A higher magnification showing proliferation of oval cells with formation of glandular structures resembling bile ducts.
This example of marked oval cell proliferation is showing bridging between adjacent portal areas.
Marked oval cell hyperplasia in an untreated male B6C3F1 mouse.